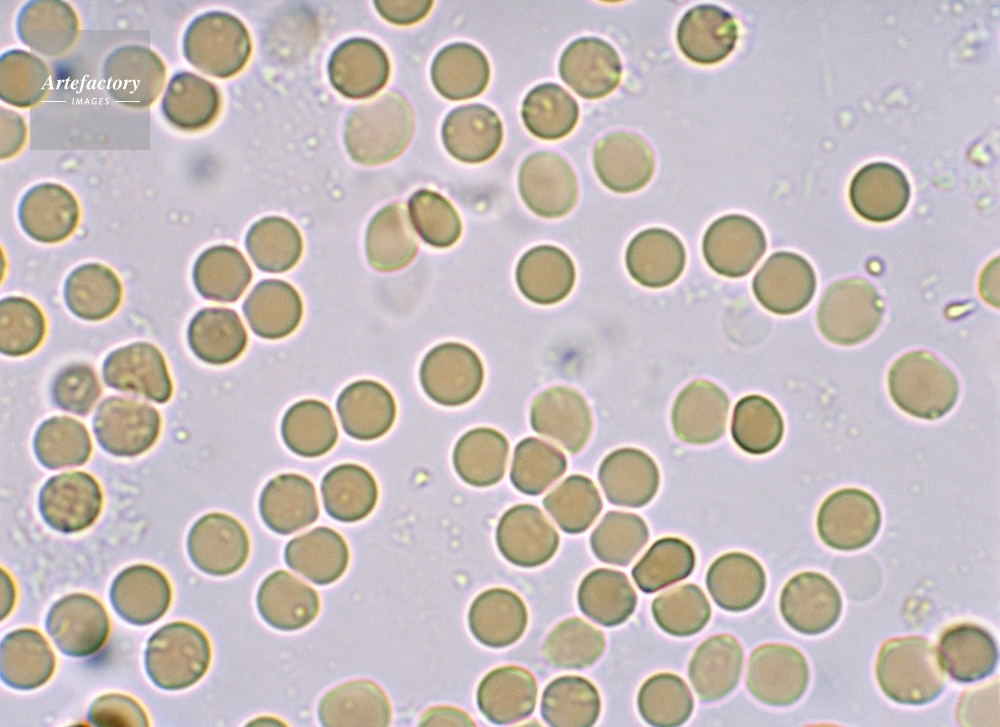

|
| 作品情報 | 使用上の注意など | |||
|---|---|---|---|---|
| 作品番号 | 27500994 | クレジット表記 | (c)OPO / Artefactory | |
| 作品タイトル | 人の赤血球と浸透圧・膨張した赤血球 | モデルリリース | なし | |
| 作家 | youichi tamura | プロパティリリース | なし | |
| キャプション | 長辺55mmの場合、500倍 低張溶液(蒸留水)中 | 制限事項 | ||
| コレクション | OPO | 注意事項 | 被写体やご利用方法によっては、事前に肖像権・商標権等に関する使用許可の取得が必要となる場合がございます。 | |
| ソース | ピクセル数 | 4105px × 2985px | ||
| 撮影地 | 印刷サイズ | 29.8cm × 21.7cm | ||
| 撮影年月日 | データサイズ | 10.5MByte | ||
| 学術名 | ファイル形式 | JPEG | ||
| キーワード | ||||
